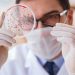

“这是一首简单的小情歌…”,一首《小情歌》,让苏打绿以一炮而红,成为很多路人认识苏打绿,并从路转粉的第一首歌,其中主唱青峰高超的词曲创作能力更是功不可没。

一手打造苏打绿的幕后推手,林暐哲与青峰的合作关系已十余年,直到去年12月青峰才与之结束合作关系,没想到换来的却是对簿公堂。
林暐哲指青峰已将在苏打绿时,所有创作歌曲的著作财产权转让给他,但他在未获得自己或所属公司同意的情况下公开演唱,违反《著作权法》,因此将他告上法庭,其他答辩人还包括公司“哈里坤的狂欢”及公司负责人廖碧珍。
林暐哲的提控最有可能造成,青峰将不能在公开场合演唱包括《小情歌》、《无与伦比的美丽》等270首由他作词作曲的歌曲,这对准备明年复出的苏打绿将是致命性的打击。
但青峰所属的环球音乐却表示,“青峰从未将词曲著作权转让予林暐哲工作室,其创作的词曲为青峰本人所拥有。青峰演唱会绝对如期举行,不说影响。”双方各执一词,逐渐演变成罗生门事件。
文:综合报导
图:网络